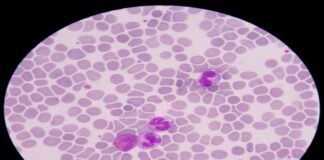
బ్లడ్ పాయిజనింగ్ ప్రాణాంతకమా.? లక్షణాలు, చికిత్స.! - Blood Poisoning: Key Symptoms and How to Treat It Blood Poisoning_ Key Symptoms and How to Treat It

పియర్- ఆరోగ్య ప్రయోజనాలు, పోషకాహారం మరియు రకాలు - Nutritional Values and Health...
పియర్ పండు ఇది అటు ఆపిల్ పండు, ఇటు జామ పండు రెండింటినీ కలగలపి తిన్నట్టుగా ఉంటుంది. తీపిగా, జ్యూసిగా ఉండే ఈ పండు తరచుగా ఆపిల్ పండు యొక్క సవితి చెల్లలు...
తులసి: పోషకాహార పవర్ హౌస్ మరియు ఆరోగ్య ప్రయోజనాలు - Holy Basil (Tulsi):...
పవిత్ర తులసి, సాధారణంగా తులసి అని పిలుస్తారు. భారతదేశంలో ఈ మొక్కను చాలా పవిత్రంగా పరిగణించి దేవతా స్వరూపంగా కొలుస్తారు కాబట్టి పవిత్ర తులసి అని పిలుస్తారు. దేశంలోని చాలా దేవాలయాల్లో మరీ...
బ్లడ్ పాయిజనింగ్ ప్రాణాంతకమా.? లక్షణాలు, చికిత్స.! - Blood Poisoning: Key Symptoms and...
మీ శరీరంలోకి ఏదోక భాగంలోకి చొచ్చుకువచ్చి సంక్రమణకు కారణమైన బ్యాక్టీరియా అలా మీ రక్తప్రవాహంలోకి ప్రవేశించినప్పుడు సెప్సిస్ అని పిలువబడే బ్లడ్ పాయిజనింగ్ జరుగుతుంది. సెప్సిస్ కు సరైన సమయంలో చికిత్స చేయని...
ప్రకాశవంతమైన, ఆరోగ్యకరమైన చర్మం కోసం 8 సహజ చిట్కాలు - 8 Natural Tips...
అందంగా కనిపించాలన్నది అందరి అబిలాష. అయితే అందంగా అన్నది తాత్కాలికంగా కాకుండా ఎప్పటికీ ఉండాలంటే అందుకు కావాల్సింది ప్రకాశించే చర్మం. మేను ఎంతటి కాంతివంతంగా ఉంటే అంత అందంగా వారి సొంతం. అందం...
కొబ్బరి: బహుముఖ ఉపయోగాలు మరియు ఆరోగ్య ప్రయోజనాలు - Coconut: Uses and Health...
కొబ్బరి మొక్క ప్రకృతి మనకు అందించిన అత్యంత ప్రసిద్ధ మరియు విలువైన మొక్క. అందుకే ఇది సాధారణంగా "ట్రీ ఆఫ్ లైఫ్" అని పిలువబడుతుంది, ఎందుకంటే ఈ చెట్టు యొక్క వివిధ భాగాల...
పులిపిర్లు: సహజంగా, వైద్య పద్ధతుల ద్వారా తొలగించే మార్గాలు - Warts Removal: Natural...
పులిపిర్లు అంటే ఏమిటి? What are warts?
పులిపిర్లు అంటే చర్మ పెరుగుదల. ఇవి హ్యూమన్ పాపిల్లోమావైరస్ (HPV) వల్ల ఏర్పడుతుంటాయి. ఈ వైరస్ దాడి వల్ల సంభవించినా ఇది హాని చేయని చర్మ...
క్యారెట్లను ప్రతిరోజు తినడం వల్ల కలిగే లాభాలు తెలుసా.? - What Are The...
క్యారెట్లు, ఒక బహుముఖ ప్రయోజనాలను అందించే కూరగాయ. దీనిని కూరలలో కన్నా అటు స్వీట్లలో ఇటు డెజర్ట్లలో ఎక్కువగా తీసుకోవడం ఇప్పటి తరానికి ఆనవాయితీగా మారింది. కానీ చాలా మంది క్యారెట్లను ఎక్కువగా ...
ముఖ్య నూనెల కలయికతో అరోమాథెరపీ సినర్జిస్టిక్ ప్రభావం - Synergistic Effects of Essential...
అరోమాథెరపీ అంటే ఏమిటి? What is Aromatherapy?
అరోమాథెరపీలో మన మానసిక స్థితి, మానసిక శ్రేయస్సు మరియు మొత్తం ఆరోగ్యాన్ని మెరుగుపరచడానికి వివిధ ముఖ్యమైన నూనెలను ఉపయోగించి సేద తరడం ఉంటుంది. ఈ నూనెలు...
కలబంద బ్యూటీ సీక్రెట్స్: మెరిసే జుట్టు, ప్రకాశించే చర్మం కోసం టిప్స్ - Aloe...
కలబంద మొక్కలు 300 కంటే ఎక్కువ జాతులు ఉన్నప్పటికీ, అలోవెరా అని కూడా పిలువబడే కలబంద బార్బడెన్సిస్ అత్యంత విలువైనది. అంతర్గతంగా మరియు సమయోచితంగా వైద్యం చేసే సామర్ధ్యాల కారణంగా ఆరోగ్య, సౌందర్య...
సెల్యులైటిస్: రకాలు, లక్షణాలు, కారణాలు, చికిత్స - Cellulitis: Types, Symptoms, Causes and...
సెల్యులైటిస్ అనేది లోతైన బాక్టీరియల్ స్కిన్ ఇన్ఫెక్షన్, ఇది సాధారణంగా చేతులు మరియు కాళ్ళను ప్రభావితం చేస్తుంది. కానీ కొందరిలో మాత్రం కళ్ళు, నోరు, పాయువు లేదా బొడ్డు చుట్టూ కూడా అభివృద్ధి...